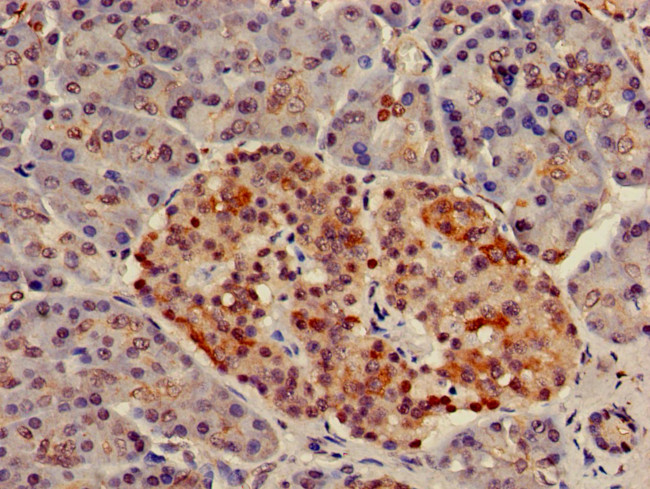
NUP107 Antibody in Immunohistochemistry (Paraffin) (IHC (P))

Search
Invitrogen
NUP107 Polyclonal Antibody
{{$productOrderCtrl.translations['antibody.pdp.commerceCard.promotion.promotions']}}
{{$productOrderCtrl.translations['antibody.pdp.commerceCard.promotion.viewpromo']}}
{{$productOrderCtrl.translations['antibody.pdp.commerceCard.promotion.promocode']}}: {{promo.promoCode}} {{promo.promoTitle}} {{promo.promoDescription}}. {{$productOrderCtrl.translations['antibody.pdp.commerceCard.promotion.learnmore']}}



Please note: We are reviewing Western blot images included in the antibody testing data in our catalog, including those provided by third parties. Unless expressly labeled or annotated as “raw-unedited”, Western blot images included in the antibody testing data in our catalog may have been edited, optimized or otherwise adjusted for presentation.
产品信息
PA5-98022
种属反应
宿主/亚型
分类
类型
抗原
偶联物
形式
浓度
规格
纯化类型
保存液
内含物
保存条件
运输条件
RRID
靶标信息
The nuclear pore complex (NPC) is a protein assembly localized at the nuclear rim and mediates macromolecular transport between the nucleus and the cytoplasm. The mammalian nucleoporin (NUP)-107 is part of the hetero-oligomeric complex that also contains NUP160, NUP133, NUP96, and mammalian homolog of yeast sec13p. While the majority of the NUP107-160 nuclear pore sub-complex localizes to the nuclear pore, a small fraction is observed at kinetochores and pro-metaphase spindle poles in mitotic cells in association with proteins such as Mad1, Mad2, Bub3 and Cdc20. Immunodepletion of the NUP107-160 complex resulted in defective spindle assembly indicating that it has multiple functions. NUP107 has recently been identified as an HIV dependency factor (HDF), suggesting that NUP107 may be an important drug target in HIV treatment. Multiple isoforms of NUP107 are known to exist.
仅用于科研。不用于诊断过程。未经明确授权不得转售。
篇参考文献 (0)
生物信息学
蛋白别名: 107 kDa nucleoporin; nuclear pore complex; Nuclear pore complex protein Nup107; Nucleoporin Nup107
基因别名: AW541137; C76801; Nup107
UniProt ID: (Mouse) Q8BH74
Entrez Gene ID: (Mouse) 103468